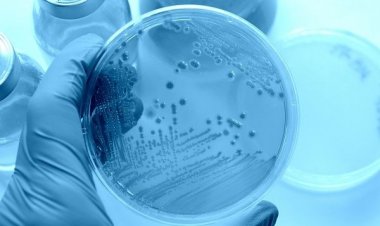
Ανακαλύφθηκαν ιοί που «παράγουν» ινσουλίνη

Ετικέτα: ΙΝΣΟΥΛΙΝΗ
Ανακαλύφθηκαν ιοί που «παράγουν» ινσουλίνη
Πιστεύουν μάλιστα ότι η νέα αυτή ανακάλυψη θα ανοίξει νέους δρόμους στην ανακάλυψη των βιολογικών μηχανισμών που παίζουν ρόλο στην εκδήλωση
Φεβ 26, 2018
Πιστεύουν μάλιστα ότι η νέα αυτή ανακάλυψη θα ανοίξει νέους δρόμους στην ανακάλυψη των βιολογικών μηχανισμών που παίζουν ρόλο στην εκδήλωση
Απρ 11, 2026
Η επίσημη πασχαλινή τοποθέτηση του Προέδρου του Δημοτικού Συμβουλίου Μυκόνου, Σταύρου...
Απρ 11, 2026
Ανακαλύψτε πώς η ΔΕΥΑ Μυκόνου θωρακίζει το δίκτυο λυμάτων σε Ακτή Καμπάνη & Γιαλό...
Απρ 11, 2026
Discover the profound spiritual side of Mykonos. Η μεγαλειώδης περιφορά του Επιταφίου...
Απρ 10, 2026
Water Alert: Έκτακτη διακοπή νερού σε Ορνό, Αγ. Ιωάννη, Κόρφο, Κανάλια, Μουρζικά,...
Απρ 10, 2026
Το πασχαλινό μήνυμα του Δημάρχου Μυκόνου Χρήστου Βερώνη για τη Λαμπρή αναδεικνύει...
Απρ 10, 2026
Joyeuses Pâques! - Γ. Πλακιωτάκης / «Ενότητα και έμπνευση για το αύριο», το μήνυμα...